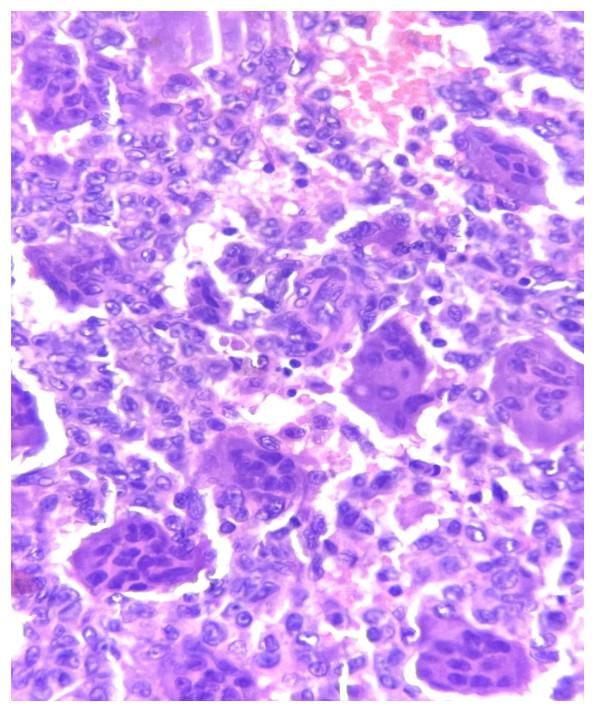

Hombre de 26 años de edad, que acude por dolor en cadera derecha de 10 meses de evolución que no mejora con ingesta de analgésicos. IDx. Quiste óseo.
Estudios de laboratorio: Hemoglobina 13.00 g/dL, hematocrito 37.5 %, LDH 298,000 UI/L.
Resonancia Magnética. Tumor en epífisis de fémur derecho, de localización excéntrica con componente sólido que condiciona edema de tejidos blandos. IDX. Tumor exofítico en fémur derecho.

1.- ¿Cuál es el diagnóstico del caso?
a) Condroblastoma.
b) Quiste óseo aneurismático.
c) Fibroma no osificante.
d) Tumor de células gigantes.
2.- Con relación a los hallazgos radiológicos de este tumor, ¿cuál es la aseveración correcta?
a) Es usual que haya reacción perióstica.
b) Cuando surge en huesos largos, suele ser lítico y excéntrico.
c) Usualmente tiene una ubicación central y muestra un margen mal definido.
d) Muestra una matriz tumoral mineralizada.
3.- Con relación a la epidemiología de este tumor, ¿cuál es la aseveración incorrecta?
a) El 10% de los casos ocurren en la segunda década de la vida.
b) La incidencia máxima se produce entre las edades de 10 y 15 años.
c) Se informa un ligero predominio femenino.
d) Representan entre el 4 y el 5 % de todos los tumores óseos primarios.
4.- ¿Cuál es el gen que esperaría encontrar mutado en este tumor?
a) USP6
b) H3-3A
c) KRAS
d) GRM1
5.- ¿Cuál es el pronóstico de este tumor?
a) Suele recurrir hasta en el 50% de los casos durante los primeros dos años posteriores al tratamiento.
b) El 40% de los pacientes desarrollan enfermedad pulmonar metastásica.
c) La invasión vascular se observa comúnmente.
d) El principal sitio de metástasis es el hígado.
1.- ¿Cuál es el diagnóstico del caso?
a) Condroblastoma.
b) Quiste óseo aneurismático.
c) Fibroma no osificante.
d) Tumor de células gigantes.
2.- Con relación a los hallazgos radiológicos de este tumor, ¿cuál es la aseveración correcta?
a) Es usual que haya reacción perióstica.
b) Cuando surge en huesos largos, suele ser lítico y excéntrico.
c) Usualmente tiene una ubicación central y muestra un margen mal definido.
d) Muestra una matriz tumoral mineralizada.
3.- Con relación a la epidemiología de este tumor, ¿cuál es la aseveración incorrecta?
a) El 10% de los casos ocurren en la segunda década de la vida.
b) La incidencia máxima se produce entre las edades de 10 y 15 años.
c) Se informa un ligero predominio femenino.
d) Representan entre el 4 y el 5 % de todos los tumores óseos primarios.
4.- ¿Cuál es el gen que esperaría encontrar mutado en este tumor?
a) USP6
b) H3-3A
c) KRAS
d) GRM1
5.- ¿Cuál es el pronóstico de este tumor?
a) Suele recurrir hasta en el 50% de los casos durante los primeros dos años posteriores al tratamiento.
b) El 40% de los pacientes desarrollan enfermedad pulmonar metastásica.
c) La invasión vascular se observa comúnmente.
d) El principal sitio de metástasis es el hígado.
Referencias bibliográficas.
- Venneker S, Szuhai K, Hogendoorn PCW, Bovée JVMG. Mutation-driven epigenetic alterations as a defining hallmark of central cartilaginous tumours, giant cell tumour of bone and chondroblastoma. Virchows Arch. 2020 Jan;476(1):135-146.
- Fujihara N, Hamada S, Yoshida M, Tsukushi S. Recurrent giant cell tumour of the distal ulna after en bloc resection with preoperative denosumab use. BMJ Case Rep. 2021 Nov 11;14(11):e245022.
- Basu Mallick A, Chawla SP. Giant Cell Tumor of Bone: An Update. Curr Oncol Rep. 2021 Mar 22;23(5):51.